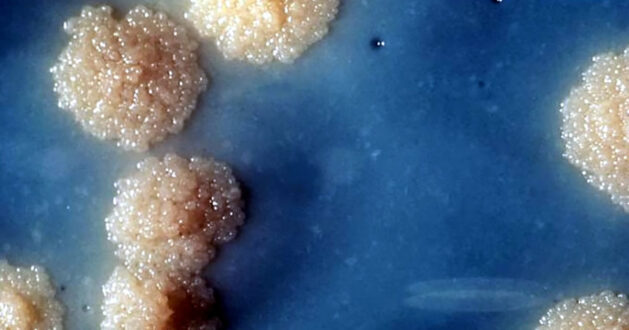

4 Haziran 2023
Sağlık yetkilileri, İspanya’nın Galiçya bölgesindeki bir okulda en az 19 şüpheli tüberküloz vakası tespit edildiğini doğruladı.
Vakalar, IES Julio Prieto Nespereira adlı okulun altıncı sınıf öğrencileri arasında görüldü.
Etkilenen herkesin evde izole edildiği ve yetkililer tarafından izlendiği bildirildi. Hastalığın varlığını doğrulamak için rutin çalışmalar sürmektedir; çünkü bir test sonucunun pozitif olması yalnızca tüberküloz bakterisi ile önceden temas edilmiş olması olasılığını göstermektedir.
Galiçya’nın Halk Sağlığı Genel Müdürlüğü, serinkanlılıklarını korumaları için bölge sakinlerine bir mesaj gönderdi. Hastalığın bulaşmasını ve okulda yeni vakaların ortaya çıkmasını engellemek için gerekli tüm faaliyetlerin yürütüldüğü konusunda güvence verdi.